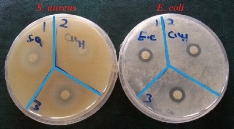
D:\xwu\Nano Biomedicine and Engineering\Articles for production\排版\10(1)\25-33 (Maryam Rad)) (2017-0065)\fig\mr8.jpg

Research Article
Effect of Incubation Time, CuSO4 and Glucose Concentrations on Biosynthesis of Copper Oxide (CuO) Nanoparticles with Rectangular Shape and Antibacterial Activity: Taguchi Method Approach
Maryam Rad 1, Mojtaba Taran 1, Mehran Alavi 2*
1 Department of Biology, Faculty of Science, Razi University P.O. Box, 6714967346, Kermanshah, Iran.
2 Department of Nanobiotechnology, Faculty of Science, Razi University P.O. Box, 6714967346, Kermanshah, Iran.
* Corresponding author. E-mail: mehranbio83@gmail.com; Tel: +98(83)-34274545; Fax: +98(831)-34274545.
Received: Dec. 8, 2017; Accepted: Feb. 26, 2018; Published: Feb. 28, 2018
Citation: Maryam Rad, Mojtaba Taran, and Mehran Alavi, Effect of Incubation Time, CuSO4 and Glucose Concentrations on Biosynthesis of Copper Oxide (CuO) Nanoparticles with Rectangular Shape and Antibacterial Activity: Taguchi Method Approach. Nano Biomed. Eng., 2018, 10(1): 25-33.
DOI: 10.5101/nbe.v10i1.p25-33.
Abstract
In nanotechnology, using of metallic nanoparticles (MNPs) has obtained major attention for over a century because of their unique properties in nano scale. In this paper, the effect of three factors (incubation time, concentrations of copper sulfate and glucose) on the biosynthesis of copper (II) oxide nanoparticles (CuO NPs) by Halomonas elongata IBRC-M 10214 and the antibacterial activity of nanoparticles were evaluated. Experiment design and analysis of Taguchi method were carried out by Qualitek-4 software. Effect of CuSO4 concentration (1.4, 2.8 and 5.6 mM), incubation time (48, 72 and 96 h) as three different levels was measured as three major factors in the biosynthesis of metallic nanoparticles. Synthesized CuO nanoparticles were characterized by utilizing ultraviolet–visible (UV-Vis) spectroscopy, X-ray diffraction (XRD), Fourier transform infra-red (FT-IR) spectroscopy and field emission scanning electron microscope (FESEM) techniques. Among the three factors, results illustrated that considerable effect was related to CuSO4 concentration. These analyses demonstrated that the average CuO nanoparticles crystalline size was 57-79 nm with rectangular shape. Also, for evaluating of antibacterial effects, maximum zone of inhibition, two important multidrug resistant pathogenesis bacteria, Escherichia coli ATCC 25922, and Staphylococcus aureus ATCC 43300 were used. Antibacterial assay of CuO nanoparticles showed antibacterial activity toward the pathogenic bacterial strains of E. coli by 5 mm and S. aureus by 5.5 mm for maximum zone of inhibition. In conclusion, this study presented simple, low expensive, eco-friendly and high productivity in the fabrication of CuO nanoparticles. In addition, these metallic nanoparticles had antibacterial effect that could be usable in medicinal aspect for fighting against prominent pathogen bacteria such as E.coli ATCC 25922 and S.aureus ATCC 43300.
Keywords: CuO nanoparticles; Biosynthesis; Halomonas elongata IBRC-M 10214; Escherichia coli ATCC 25922; Staphylococcus aureus ATCC 43300
Introduction
Generally, nanoparticles (NPs) are particles with a diameter size in the range of 1 to 100 nm (≤0.1 μm) and unique properties that mainly depend on their size [1, 2]. Compared with bulk materials, NPs have attracted more attention due to their unique specific properties such as higher surface area to volume (SA:V) ratio [3, 4], which results in various applications in biology and medicine [5, 6], optical sensors [7], cosmetics [8], food industry and household products [9, 10]. These applications are resulted from SA:V ratio of NPs that lead to NPs with high surface energy [11]. In nanotechnology, using of metallic nanoparticles (MNPs) has been prominent scientific attraction for over a century due to their huge potential and function [12]. Comparing to other MNPs, copper NPs (Cu and CuO NPs) preparation was more achievable with advantages of less cost than gold (Au) and silver (Ag) NPs [13]. Similar to other noble MNPs, Cu NPs showed excellent electrical [14] and thermal conductivity [15] and antimicrobial activities [16-19]. There are several ways for synthesis of copper NPs [20]. The first reported method for NPs synthesis was the chemical method of co-precipitation with disadvantages of NPs agglomeration, lack of size uniformity and using of toxic chemicals. This method used nucleation and growth processes during NPs formation [21]. Also, synthesis of cupric oxide NPs (CuO NPs) with spherical-like shape was carried out by the planetary ball mill method [22]. In return, NPs synthesis through biological techniques specifically applying microorganisms emerged as an eco-friendly, clean and benefit alternative to physicochemical techniques [23]. In recent years, green methods have attained tremendous attention in synthesis of pure or oxide MNPs [24-27]. However, not real green nature of these methods is a major problem [28]. Generally, plant and bacteria are two important sources for green synthesis of NPs [29, 30]. In contrast to the herbal type, biosynthesis of NPs by bacteria does not have the disadvantages of high polydispersity index (PDI) in NPs production due to the lack of multiple secondary metabolites including polyphenols and flavonoids [31]. In the case of bacterial approach for biosynthesis of NPs, it can utilize culture supernatant [32, 33], bacterial biomass [34], cell-free extract [35], and bacterial derived components [36]. Therefore, in this study, we used culture supernatant as the extracellular approach of biosynthesis CuO NPs due to the simple recovery of NPs compared to the intracellular mode [37]. In the previous study, we used selected strain Halomonas elongata IBRC-M 10214 to reduce Cu2+ ion to pure Cu NPs and also evaluated the effect of three factors (CuSO4, glucose, NaCl concentrations) on the biosynthesis of Cu NPs. In the present study, in addition to synthesis of CuO NPs, we also used incubation time (48, 72 and 96 h) as different influencing factors in this process. ultraviolet–visible (UV-Vis) spectroscopy, X-ray diffraction (XRD), Fourier transform infra-red spectroscopy (FT-IR), and scanning electron microscopy (SEM) techniques were applied for NP characterization. Also, antibacterial effects of the final reaction were measured on two pathogenesis bacteria strain with multidrug resistant property, Escherichia coli ATCC 25922 and methicillin-resistant Staphylococcus aureus ATCC 43300 (MRSA).
Experimental
Experimental design by Taguchi method
Taguchi experimental design method has the advantages of reduced number of experiments with data collection quality and quantified and comparative analysis of the factor effects [38]. In this design of experiment, the proper selection of factors and their levels are first step [39]. Therefore, in order to optimize experimental conditions, all the combination experiments were conducted using the assigned parameter values [40]. Qualitek-4 software was utilized to design and analyze Taguchi experiments [41, 42]. Table 1 demonstrates variable factors and their levels in this experiment design.
Table 1 The orthogonal array of Taguchi experimental design for biological synthesis of CuO NPs
|
Experiment number |
Glucose concentration (mM) |
Incubation time (h) |
CuSO4 concentration (mM) |
OD (a.u) |
|
1 |
0.28 |
48 |
1.4 |
0.526 |
|
2 |
0.28 |
72 |
2.8 |
0.414 |
|
3 |
0.28 |
96 |
5.6 |
0.895 |
|
4 |
0.39 |
48 |
2.8 |
0.428 |
|
5 |
0.39 |
72 |
5.6 |
0.463 |
|
6 |
0.39 |
96 |
1.4 |
0.444 |
|
7 |
0.56 |
48 |
5.6 |
0.839 |
|
8 |
0.56 |
72 |
1.4 |
0.450 |
|
9 |
0.56 |
96 |
2.8 |
0.524 |
CuO NPs biosynthesis and preparation of supernatant
Halomonas elongata IBRC-M 10214 with the property of copper resistant was gained from bacterial archive of Razi University of Kermanshah and was cultivated in the basal medium containing (g/L) glucose, 10; MgSO4, 1.4; NaCl, 150; NH4Cl, 2.3; K2HPO4, 0.6; FeSO4, 0.001 and 10% (V/V) [43, 44]. Inoculum was transferred into 100 mL Erlenmeyer flasks and incubated in a shaker at 28 ̊C for one week. According to the details of the experiment design, the growth medium was supplemented with various nutrient compositions by varying glucose (Table 2). Amount of 1.5 cc from each Erlenmeyer flask was centrifuged at 12,000 rpm for 5 min. Afterwards, 1 cc of supernatant was poured inside the test tube followed by treating with different concentrations of copper sulfate (CuSO4) (Table 2-5). Finally, the resulted solution was placed at 28 ̊C in a shaking incubator at 120 rpm [45].
Table 2 Effects of three different factors on the CuO NPs biosynthesis
|
Level 3 (value) |
Level 2 (value) |
Level 1 (value) |
Factors |
|
0.604 |
0.445 |
0.611 |
Glucose concentration |
|
0.62 |
0.442 |
0.597 |
Incubation time |
|
0.732 |
0.455 |
0.473 |
CuSO4 concentration |
Table 3 Estimation of factor interaction on CuO NPs biosynthesis by archaebacteria
|
Optimum conditions |
Columns |
Intensity of interactions (%) |
Columns |
Effects of factor pairs based on (SI) |
Factors
|
|
[3, 1] |
3 |
15.28 |
2 × 1 |
Glucose × incubation time |
1 |
|
[3, 1] |
2 |
9.97 |
3 × 1 |
Glucose × CuSO4 |
2 |
|
[3, 3] |
1 |
6.44 |
3 × 2 |
Incubation time × CuSO4 |
3 |
Table 4 Variance analysis for biosynthesis of CuO NPs by archaebacterium
|
Percent (%) |
Pure Sum (Ś ) |
F-Ratio (F) |
Variance |
Sum of Sqrs. |
DOF (f) |
Factors |
|
49.732 |
0.132 |
12.097 |
0.072 |
0.144 |
2 |
CuSO4
|
|
15.536
|
0.041
|
4.466 |
0.026 |
0.053 |
2
|
Glucose concentration |
|
16.805 |
0.044 |
4.75 |
0.028 |
0.056 |
2 |
Incubation Time |
Table 5 Optimum conditions of NP synthesis by Archaebacteria
|
Contribution |
Level |
Factors |
|
0.058 |
1 |
Glucose |
|
0.067 |
3 |
Incubation time |
|
0.178 |
3 |
CuSO4 |
|
0.302 |
- |
Total contribution from all factors |
|
0.553 |
- |
Current grand average of performance |
|
0.856 |
- |
Expected result at optimum condition |
NPs characterization
The intensity of absorption peaks of NPs was examined by UV-Vis spectrophotometer (Tomas, UV 331) from wavelengths of 300 to 800 nm. FT-IR measurements were done by spectrophotometer (Germany, Bruker, Model: ALPHA). The prepared annealed samples were analyzed by XRD, SEM due to evaluation of structure, morphology and elemental composition [19]. Crystallographic study was carried out using EQUNIOX 3000, diffractometer in the scanning range of 20˚ - 70˚ (2θ) using Cu Ka radiations of wavelength with 1.5406 Å. Also, Model XL30, Philips, Eindhoven, Field Emission Scanning Electron Microscope (FESEM) was used to study the morphology of the NPs and the elemental analysis.
Antibacterial activity
Two strains of pathogen bacteria, Escherichia coli ATCC 25922 and Staphylococcus aureus ATCC 43300 were applied for indicating the activity of antibacterial properties of CuO NPs by disk diffusion method. According to standard NCCLS metgodology, 0.5 McFarland standard of the clinical pathogen bacteria were cultivated in Muller Hinton agar (MHA) plates by sterile cotton swabs; 5 mm diameter disks were prepared with the help of a sterilized steel cork borer [46-48]. Then, different concentrations of CuO NPs (1.4, 2.8 and 5.6 mM of CuSO4) were loaded in different disks and followed by placing the disks on agar and incubation of the plates at 37 ̊C for 48 h.
Results and Discussion
UV-Vis spectroscopy analysis
The formation of CuO NPs was carried out by the culture supernatants of Halomonas elongata IBRC-M 10214. In this case, bacterial strains were incubated for reduction of copper ions to CuO NPs; there was rapid reaction (rapid color change from blue to green at 10 min). Fig. 1 shows the appearance of a green color in the reaction vessels in flasks of 8 and 9, suggesting the formation of colloidal CuO NPs. The UV-Vis absorption spectra of the supernatant were evaluated in the range of 400-1000 nm by a double beam UV-Vis spectroscopy. As shown in Fig. 2, a strong broad absorption band was located between 800 and 850 nm for CuO NPs prepared by this bacterium. The absorbance in the range of 800-850 nm was higher in 0.01 M of CuSO4 concentration. The excitation of surface plasmon vibration of CuO NPs can be the cause of color change [49]. Spectrum absorption of UV-Vis spectra for this solution illustrated a distinct absorption peak in the region of 800-850 nm wavelengths (Fig. 2). According to special particle properties such as size, shape and capping agents, the precise position of surface plasmon resonance (SPR) band may be shifted. Biogenic synthesis of Cu NPs using citron juice (Citrus medica Linn.) characterized by UV-Vis spectrophotometer demonstrated a typical SPR at about 631 nm wavelength [50].

Fig. 1 Solutions of copper sulfate after exposure to the culture supernatant of Halomonas elongata IBRC-M 10214 (from left to right 1.4, 2.8 and 5.6 mM)

Fig. 2 UV-Vis spectrum of CuO NPs produced by Halomonas elongata IBRC-M 10214 in three levels of concentrations: (a) 5.6, (b) 2.8 and (c) 1.4 mM.
Taguchi design
The selection of optimum conditions for achieving high quantity and quality of MNPs synthesis is an important task. In this case, these conditions were indicated only through selection of metal salt concentrations as one factor from the results of previous reports. However, this approach cannot ensure optimum conditions due to a lack of evaluating of other factors in their suitable range [51]. Basically, Taguchi method is a considerable approach to remove these obstacles in experiment design [52]. Therefore, similar to our previous studies, Taguchi method was used for achieving optimum conditions based on the selection of three parameters (incubation times, CuSO4 and glucose concentrations) [25, 33, 53]. The orthogonal array of Taguchi experimental design for biological synthesis of CuO NPs was demonstrated in Table 1. Table 2 illustrates effects of three different factors (CuSO4 concentration, glucose concentration and incubation time) on the CuO NPs biosynthesis by H. elongata IBRC-M 10214. CuSO4 concentration in level 3 (0.732), glucose concentration in level 1 (0.611) and incubation time in level 3 (0.62) had higher effect on the CuO NPs biosynthesis (Fig. 3). As shown in this figure, CuSO4 concentrations had more effect on CuO NPs biosynthesis compared to other parameters. These values in previous investigation were 0.904 (level 1) and 0.819 (level 2) for CuSO4 and glucose parameters respectively [33]. The interaction effect of factors was showed in Table 3. These interactions were based on the amount of measured factors that were changed from 15.28 to 6.44. The intensity of interaction effect between two factors with lower effect in MNPs synthesis was related to incubation time × CuSO4 with 6.44%. Glucose × incubation time had higher effect on CuO NPs production. In total, this table illustrates optimum conditions of CuO NPs biosynthesis in interaction of glucose and incubation time as major factors in growth of H. elongata IBRC-M 10214. Table 4 illustrates the ANOVA table (analysis of variance) of three factors (CuSO4 concentration, glucose concentration and incubation time) in the green synthesis of CuO NPs by archaebacterium. As observed, the significant factors for controlling NP synthesis in samples were CuSO4 (49.73%), incubation time (16.8%) and then glucose concentration (15.53%), respectively. Therefore, the influence of CuSO4 amount was higher than other factors. Also, the contribution of each factor is demonstrated in Table 5. Data of this table show that CuSO4 concentration had a major role by 0.856% efficiency in the biosynthesis of CuO NPs under optimum conditions.

Fig. 3 Taguchi results of average effect of (a) CuSO4 concentration, (b) glucose concentration and (c) incubation time.
FT-IR analysis
This analysis was used for the evaluation of interaction of CuO NPs with their medium components. Fig. 4 illustrates a C=O vibration band at 1589.67/cm. In addition, the spectrum demonstrates 3377/cm, 2274.96/cm, 1105.36/cm, 1050.94/cm, 769.02/cm, 642.30/cm, 601.12/cm and 468.83/cm for O-H, C=C, C=O, C-H, C-Cl, C-H, C-Cl and C-Br bonds, respectively. In this case, interactions between NPs and carbonyl (C=O) and hydroxyl groups (-OH) of medium components were the major cause of these stretching bonds [54]. Similar results were reported by Usman and coworkers [19]. FT-IR spectroscopic analysis illustrates that the culture supernatant of Halomonas elongata IBRC-M 10214 had the ability to perform dual functions of reduction and stabilization of CuO NPs. When metal NPs were produced in the solution, they must be stabilized against the Van der Waals forces of attraction which may otherwise result in coagulation (Fig. 6). The FT-IR analysis revealed that the protein component in the form of enzyme nitrate reductase and the rhamnolipids in the culture supernatant of Pseudomonas aeruginosa might be responsible for the reduction and as a capping material in the extracellular synthesis of NPs [55].

Fig. 4 FT-IR spectra of biosynthesized CuO NPs by Halomonas elongata IBRC-M 10214. Different peaks illustrate major functional groups
XRD analysis
As shown in Fig. 5, a high crystalline level of CuO NPs sample could be seen with diffraction angles of 36.12, 39.32, 49.74, 58.69 and 69.22 which corresponded to the characteristic face centered cubic (fcc) of copper lines indexed at (002), (111), (202), (202) and (113), respectively [19]. Impurities such as Cu and Cu2O may be effective on the absence of any noticeable peak in the pattern. Also, the grain sizes of estimated NPs were 57-79 nm using Debye-Scherer Eq. (1):
![]() , (1)
, (1)
where k, known as Scherer’s constant, ranged from 0.9 to 1.0, λ is 1.5418 Å, which was the wavelength of the XRD source, β1/2 was the width of the XRD peak at half height and θ was the Bragg angle (Fig. 5). However, XRD measurement revealed that the NPs initially were formed as colloids, tending to grow and react with environment oxygen [56]. Analysis of SEM demonstrated that CuO NPs were biosynthesized as rectangle shape (Fig. 6). Also, the XRD spectrum showed the characteristic Bragg peaks of 111, 200, 220 and 311 facets of the face centered cubic NPs and indicated the crystallinity nature of these NPs [55].

Fig. 5 XRD spectrum of CuO NPs synthesized from 0.56 M CuSO4 treated H. elongata IBRC-M 10214 cell free supernatant at 28 ˚C.

Fig. 6 SEM images (magnification range of 10, 5 and 2 μm) of CuO NPs with rectangular shape produced by the culture supernatant of Halomonas elongata IBRC-M 10214.
Antibacterial activity
Results of bactericidal effect of the MNPs on the pathogen bacteria are showed in Fig. 7 and 8. Due to the evaluation of antibacterial effects, inhibition zone diameter (IZD) was measured for two important multidrug resistant pathogenesis bacteria, Escherichia coli ATCC 25922 (negative gram) and Staphylococcus aureus ATCC 43300 (positive gram) bacteria. Three levels of CuO NPs (1.4, 2.8 and 5.6 mM of CuSO4 concentrations) had antibacterial effect on E.coli (8, 8.6 and 10 mm). In case of S. aureus, there were 8.4, 6 and 11 mm of IZD (Fig. 7). Compared to our previous investigation, E. coli and S. aureus had maximum IZD with 10 and 8.7 mm for biosynthesized Cu NPs [33]. Antibacterial activities of several metallic NPs including Au, Ag, TiO2, ZnO were investigated. The antimicrobial activity of Cu nanocomposite with SiO2 against Penicillium citrinum and Candida albicans has been reported [57]. Treatment of cotton fabrics by Cu NPs increased their resistance against microbial attack [58]. Suspension of CuO NPs by minimum bactericidal concentrations ranging from 100 μg/mL to 5000 μg/mL illustrated antibacterial activity against S. aureus and E. coli [59]. Also, mono-disperse Cu NPs with average diameter 50 nm showed antimicrobial effects on S. sureus (MRSA) and Candida species [60]. Growth reducing and killing of bacteria by antibacterial agents such as NPs are prominent activities [61]. Bacteria are divided into two major types (gram negative and gram positive) based on cell wall structure [62]. Peptidoglycan are important constitutes of this structure which can be affected by MNPs. In this case, formation of “pits” in the cell wall of the bacteria could be resulted from NPs interaction with bacteria surface [63]. Antibacterial activity of MNPs might be resulted from the attaching of copper ions (released by the NPs) to the negatively charged bacterial cell [64].

Fig. 7 IZD of CuO NPs against E.coli ATCC 25922 and S.aureus ATCC 43300.
Fig. 8 Disc diffusion assay of CuO NPs on S.aureus ATCC 43300 and E.coli ATCC 25922
Conclusions
There are many investigations about biosynthesis of NPs by plant, fungi and bacteria. In this study, CuO NPs with cubic shapes and average crystaline sizes in the range of 57-79 nm and the fcc crystal structure were synthesized in a green method by Halomonas elongata IBRC-M 10214. UV-Vis, XRD, FT-IR were used to characterize the NPs. Based on this study, green method is easy and safe for CuO NPs synthesis with relative purity of the NPs obtained. In this biosynthesis method, stabilizing of CuO NPs is easily possible without using any chemical capping agents which are toxic and expensive. Also, these NPs have antibacterial effect that can be usable in medicinal aspect for attacking striking pathogen bacteria such as E.coli ATCC 25922 and S.aureus ATCC 43300. In general, this study reports a simple, eco-friendly, low-expense and high-productivity synthesis of CuO NPs.
Acknowledgements
The authors wish to appreciate Razi University for providing necessary facilities to carry out this work.
Conflict of Interests
The authors declare that there are no conflicts of interests regarding the publication of this manuscript.
References
Copyright© Maryam Rad, Mojtaba Taran, and Mehran Alavi. This is an open-access article distributed under the terms of the Creative Commons Attribution License, which permits unrestricted use, distribution, and reproduction in any medium, provided the original author and source are credited.